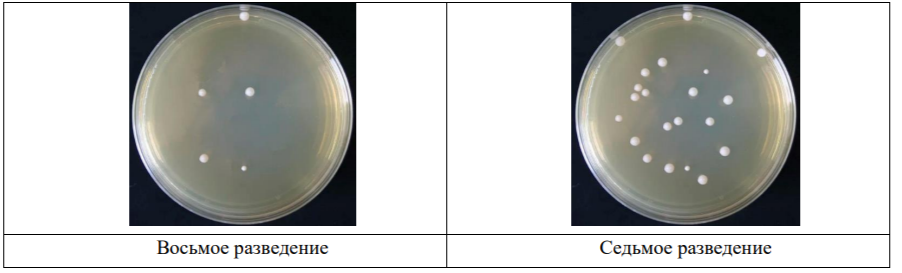

31.01.2025 — Официальные задания и ответы к заключительному этапу Многопрофильной инженерной олимпиаде «Звезда» по Биотехнологии 9-10 класс, проходящая 31 января 2026 г.
Олимпиада «Звезда» по Биотехнологии
Скачать полные ответы и задания
9-10 класс
Задание 1. В процессе ферментации молока постепенно увеличивается количество бактерий, продукт сквашивается и превращается в биойогурт. Представить этот процесс можно графически. По данным таблицы постройте график изменения количества микроорганизмов в процессе сквашивания и по графику определите, какое количество бактерий было в биойогурте через 9 ч сквашивания (КОЕ – колониеобразующие единицы) /г).

Задание 2. Для определения количества живых бактерий в йогурте используют метод посева на питательную среду. Для проведения посева вашего йогурта вы подготовили ряд разведений и посеяли каждое из них на чашки Петри. На рисунке представлены результаты посевов на двух чашках Петри. Определите среднее количество микроорганизмов в 1 г йогурта по данным картинкам. В ответе укажите количество бактерий в КОЕ /г.
Задание 3. Учитель попросил ребят самостоятельно изготовить биойогурт дома и принести в лабораторию для исследований 1 кг продукта. Для приготовления биойогурта необходим термостат, в котором происходит процесс ферментации. У одного из ребят дома оказалась йогуртница, в которой и решили проводить ферментацию молока для получения биойогурта. В йогуртнице 6 стаканов цилиндрической формы со следующими параметрами: высота – 80 мм, диаметр – 76 мм. Определите, какое количество стаканов с молоком необходимо поставить на ферментацию для получения заданного количества биойогурта, если известна плотность молока – 1027 кг/м3. Также вы опытным путем установили с помощью ареометра плотность биойогурта как представлено на рисунке. Для решения задачи необходимо вспомнить формулу для определения объема цилиндра.

Задание 4. Известно, что многие растения обладают уникальными свойствами благодаря содержанию биоактивных веществ. Определенные части растений успешно используют как источник различных нутриентов для обогащения продуктов питания. Такие продукты могут быть хорошей нутритивной поддержкой в диетическом питании при определенных заболеваниях человека.
Творческая задача: разработать концепцию обогащенного биойогурта Для этого вам необходимо решить ряд подзадач.
Для какой группы населения вы бы рекомендовали свой продукт с учетом его полезных свойств. Обоснуйте, укажите возможные заболевания или отклонения в состоянии здоровья выбранных групп населения.
Выберите вид бактерий, которые вы бы добавили в молоко, чтобы получить йогурт.
Выберите известное вам по свойствам и биологическим особенностям растение, которое можно использовать как потенциальное сырье для обогащения йогурта полезными ингредиентами.
Какую часть выбранного растения вы рекомендуете использовать? Обоснуйте свой выбор с точки зрения фитохимических свойств выбранного растения и его частей.
Как вы бы извлекли полезные компоненты из выбранной части растения, применив известные химические и биотехнологические подходы. На каком этапе технологического процесса изготовления йогурта вы бы внесли полезный компонент? Обоснуйте выбранную технологию и изобразите ее в виде технологической схемы.
→ Узнать ответ